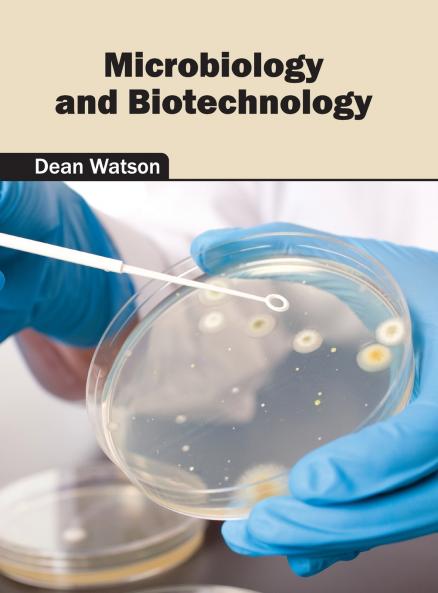
Microbiology and Biotechnology

English
Hardback
₹14273
₹16342
12.66% OFF
(All inclusive*)
Delivery Options
Please enter pincode to check delivery time.
*COD & Shipping Charges may apply on certain items.
Review final details at checkout.
Looking to place a bulk order? SUBMIT DETAILS
Delivery Options
Please enter pincode to check delivery time.
*COD & Shipping Charges may apply on certain items.
Review final details at checkout.
About The Book
Description
Author
Biotechnology plays a vital role across various industries to develop and manufacture products that involve biological systems and organisms. Microbial organisms are widely used in food processing and pharmaceutical industries. They are also utilized in distinct industrial processes like fermentation and waste water treatment. Some of the diverse topics encompassed within this book are microbial cell biology environmental microbiology and engineering genetics enzymology applied genetics etc. The topics in this book are compiled by internationally renowned panel of authors and industry experts. It will serve as a reference to a broad spectrum of readers.
Details
ISBN 13
9781682861790
Publication Date
-23-05-2016
Pages
-228
Weight
-700 grams
Dimensions
-216x280x14.29 mm